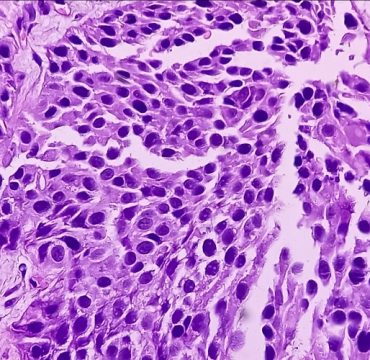
JJP-1008 as a Novel Checkpoint Inhibitor
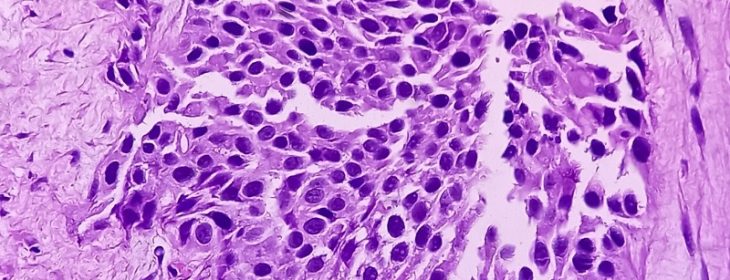
JJP-1008 as a Novel Checkpoint Inhibitor
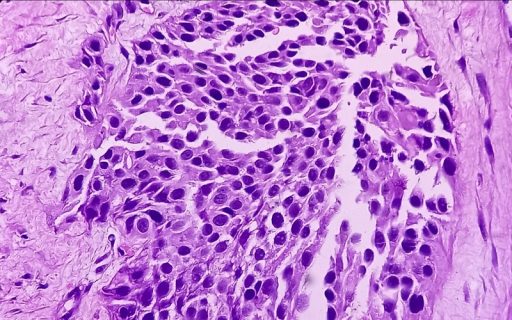
JJP-1008 as a Novel Checkpoint Inhibitor

JJP-1008 as a Novel Checkpoint Inhibitor
JJP Biologics is a Polish biotechnology company developing novel biologics for the treatment of a range of disease indications. We have multiple (pre)clinical programs that we plan to develop until clinical proof of concept. JJP-1008 is a pioneering humanized and stabilized IgG4‑κ monoclonal antibody targeting CD270.
High HVEM expression on tumors correlates with poor prognosis and an immunosuppressive tumor microenvironment, making it an ideal target for immuno-oncology interventions. Tumors, including melanoma, breast, lung and colon cancers, exploit CD270 signaling pathways to escape immune attack, leading to disease progression and resistance to existing immunotherapies.
Through our deep mechanistic insights, we engineered JJP-1008 to offer a much-needed novel treatment option for patients who do not respond to current PD‑1/PD-L1 therapies, as identified through tumor expression profiling of CD270.
Show more
JJP-1008 blocks the immunosuppressive interactions of CD270 with inhibitory receptors CD160 and BTLA, while preserving and even enhancing immune activation through CD258 (LIGHT). This balanced modulation reactivates the immune system’s ability to recognize and kill cancer cells, overcoming tumor immune evasion.
Preclinical studies have demonstrated anti-tumor activity of JJP-1008 in both in vitro and in vivo models, including melanoma, supporting its potential as a transformative checkpoint inhibitor and potential broad application in solid tumors. The program is currently advancing through preclinical development, with ongoing CMC activities supporting future clinical translation.
JJP Biologics is a Polish biotechnology company developing novel biologics for the treatment of a range of disease indications. We have multiple (pre)clinical programs that we plan to develop until clinical proof of concept. JJP-1008 is a pioneering humanized and stabilized IgG4‑κ monoclonal antibody targeting CD270.
Show more
High HVEM expression on tumors correlates with poor prognosis and an immunosuppressive tumor microenvironment, making it an ideal target for immuno-oncology interventions. Tumors, including melanoma, breast, lung and colon cancers, exploit CD270 signaling pathways to escape immune attack, leading to disease progression and resistance to existing immunotherapies.
Through our deep mechanistic insights, we engineered JJP-1008 to offer a much-needed novel treatment option for patients who do not respond to current PD‑1/PD-L1 therapies, as identified through tumor expression profiling of CD270.
JJP-1008 blocks the immunosuppressive interactions of CD270 with inhibitory receptors CD160 and BTLA, while preserving and even enhancing immune activation through CD258 (LIGHT). This balanced modulation reactivates the immune system’s ability to recognize and kill cancer cells, overcoming tumor immune evasion.
Preclinical studies have demonstrated anti-tumor activity of JJP-1008 in both in vitro and in vivo models, including melanoma, supporting its potential as a transformative checkpoint inhibitor and potential broad application in solid tumors. The program is currently advancing through preclinical development, with ongoing CMC activities supporting future clinical translation.

Agata Drewniak-Maksymów
Agata Drewniak-Maksymów is a Translational Science Lead at JJP Biologics, specializing in oncology, immunology, and precision medicine. With 10 years of experience in the biopharmaceutical industry, she has held leadership roles at Sanofi and Kiadis Pharma, where she led biomarker and translational strategies across immuno-oncology and cell therapy programs.
Her work focuses on integrating biomarker-driven approaches to support proof of mechanism, patient selection, and clinical development. Holding a PhD in Immunology from University of Amsterdam , she is also a lecturer and scientific consultant, bridging complex science with clinical application.
Find out more about JPP Biologics.
Agata Drewniak-Maksymów is a Translational Science Lead at JJP Biologics, specializing in oncology, immunology, and precision medicine. With 10 years of experience in the biopharmaceutical industry, she has held leadership roles at Sanofi and Kiadis Pharma, where she led biomarker and translational strategies across immuno-oncology and cell therapy programs.
Show more
Her work focuses on integrating biomarker-driven approaches to support proof of mechanism, patient selection, and clinical development. Holding a PhD in Immunology from University of Amsterdam , she is also a lecturer and scientific consultant, bridging complex science with clinical application.

Read the Abstracts from Our Invited Speakers
Cancer Biology
- AllergoOncology: Lessons Learned from the Allergy-Glioblastoma Connection
Aurélie Poli, Luxembourg Institute of Health, LUXEMBOURG
- Cytotoxic NK Cells Impede Response to Checkpoint Immunotherapy in Melanoma with an Immune-Excluded Phenotype
Joanna Poźniak, KU Leuven, BELGIUM
- Inducing Immunogenic Tertiary Lymphoid Structures Across Cancer Types With Dendritic Cell Reprogramming
Camille Chatelain, Lund University, SWEDEN
- The Role of ILC2 in Tissue Homeostasis and Neoplasia
Tim Halim, Cancer Research UK Cambridge Institute, UNITED KINGDOM
Cancer Neuroscience
- Latent Neuropathy in Colorectal Cancer: Implications for Cancer Survivorship
Andrew Shepherd, University of Texas MD Anderson Cancer Center, USA
- Remodelling of the Bone Microenvironment During Cancer Infiltration: Insights from Multiplex Imaging and Spatial Transcriptomics
Christina Møller Andreasen, University of Southern Denmark, DENMARK
- Enteric Nervous System-Derived VIP Restrains Differentiation of LGR5+ Stem Cells Towards the Secretory Lineage Impeding Type 2 Immune Programs
Christoph Klose, Charité – Berlin University Medicine, GERMANY
Cancer Therapy
- Targeting the Dark Matter of Cancer with AI-Designed Mini Binder
Tobias Bald, University of Bonn, GERMANY
- Engineering Nanomedicines for Targeted Neuroimmune Modulation
Helena Florindo, University of Lisbon, PORTUGAL
- Potentiating Immunotherapy of Urological Cancers with Oncolytic Viruses
Gabri van der Pluijm, Leiden University Medical Center, THE NETHERLANDS
- Strategic Priorities in Cancer Therapy: Navigating the 2026 Cancer Mission Calls
Industry Contact Point, Łukasiewicz – PORT, POLAND
- Cancer Neuroscience of Brain TumorsKEYNOTE SPEAKER
Frank Winkler, Universitätsklinik Heidelberg, GERMANY
- Spatial Reprogramming of Immune Surveillance in Breast Cancer: From Immune Control to Immune Failure
Sheeba Irshad, King’s College London, UNITED KINGDOM
- The War Against Glioblastoma Needs More Than Standard of Care
Stefaan Van Gool, IOZK Immun-Onkologisches Zentrum Köln, GERMANY
- Uncovering the Spatial Regulation of γδ T Cells: Toward Receptor-Guided Immunotherapy
Jürgen Kuball, University Medical Center Utrecht, THE NETHERLANDS
- Latest Advances in CAR‑T Therapy in Lymphoma: Where Are We and Where Are We Going?
Jarosław Dybko, Lower Silesian Oncology Center in Wroclaw, POLAND
- Expanding CAR Targets to Non Protein Antigens
Sébastien Wälchli, Oslo University Hospital, NORWAY
- Advancing BIA-ALCL Research Through a UK – PORT Alliance — From Biobanking to Immune Discovery
Helen Kakkassery, King’s College London, UNITED KINGDOM
PORT for Business — Company Session
- From Sample to Insight: Advanced Analytics for Oncology Research
Malwina Woźniak, Łukasiewicz – PORT, POLAND
- Beyond glioblastoma — WPD Pharmaceuticals
Marek Sipowicz, WPD Pharmaceuticals, POLAND
- The Development of USP7 Inhibitor for Cancer Immunotherapy
Zbigniew Zasłona, Molecule, POLAND
- Leveraging Cancer Biology for Therapeutic Innovation: Clinical and Discovery Advances at Ryvu
Milena Mazan, Ryvu Therapeutics, POLAND
- Transforming Multimodal Complexity into Precision Oncology Insights
Marek Kudła, Ardigen, POLAND
- TBC
Artur Wnorowski, Biotechna, POLAND
- Development of Biological Drugs for Oncological Indications at Mabion
Jakub Knurek, Mabion, POLAND

